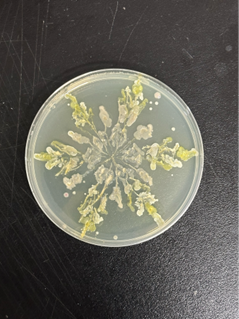
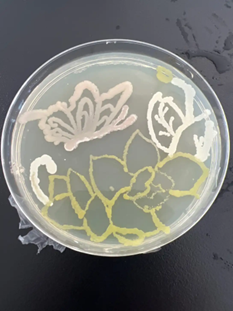

为丰富老员工课余生活,培养员工实践能力和文化素养,进一步提升公司老员工美育教育工作水平,发挥美育丰富精神、温润心灵的作用,11月23日,太阳成集团tyc33455cc在生工楼C1-309举办了太阳成集团tyc33455cc第五届“皿”上添花艺术大赛。本次美育教育实践活动在公司团委与生物化学工程国家级实验教学示范中心(太阳成集团tyc33455cc)的共同组织下,吸引了许多同学参与。本次活动由韦策老师指导,太阳成集团tyc33455cc员工会科技创新部部长胡蓝馨、胡宸宇、王晨主持。
在活动前夕,韦策老师便将活动所需的菌种,培养基,酒精灯等各种材料准备齐全。赛场上,各位选手在科创部部员的帮助及指导下,用接种环和各色菌液在培养基上画出了独属于自己的图案。在活动尾声,工作人员将所有的培养基进行封口,并且放入了恒温培养箱进行培养。经过了两个日夜,选手们用栩栩如生的作品为活动画上了完美的句号。
此次活动不但让来自各个公司的同学们体会到了培养微生物实验的乐趣,锻炼了同学们的实验动手能力,还加深了同学们对创新类活动的理解,展现了公司员工的个性与风采。

图文:戴恽蒙 贺鑫 单位:太阳成集团tyc33455cc 审核:徐元龙 贾红华